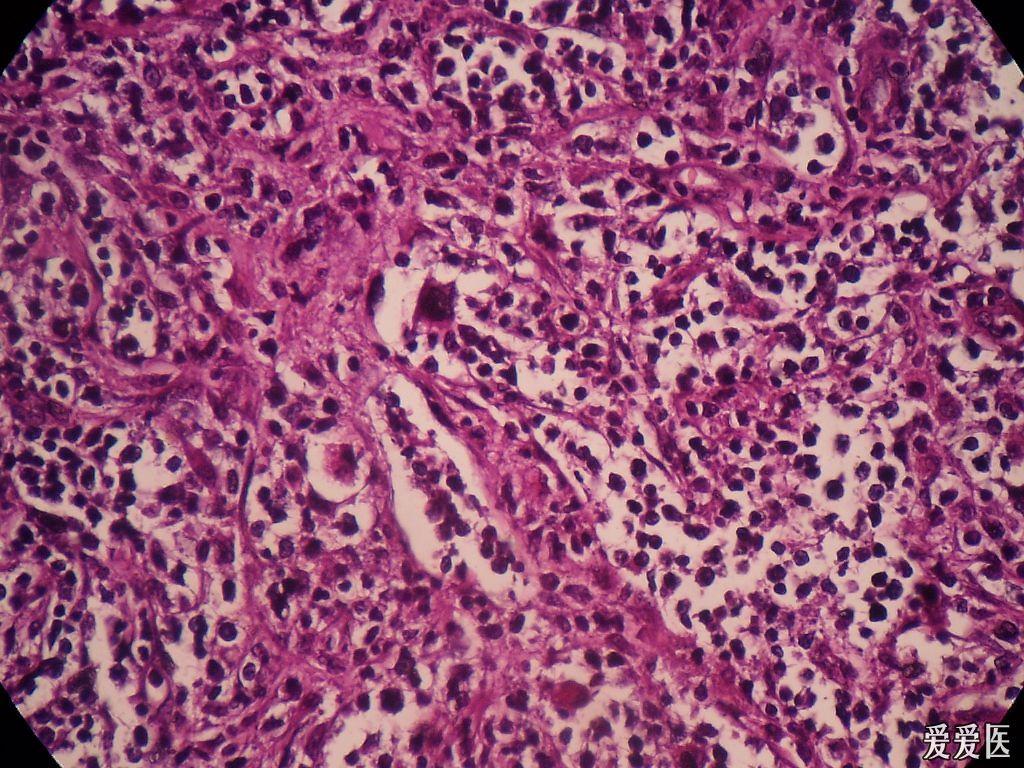
非霍奇金淋巴瘤吗? 求助!

非霍奇金淋巴瘤

非霍奇金淋巴瘤弥漫大b细胞淋巴瘤抗瘤日志用药费用禁食减少身体不适
图片尺寸1280x2278
临床病例分析一例非霍奇金淋巴瘤患者的药学监护
图片尺寸920x690
显微镜下的非霍奇金淋巴瘤
图片尺寸1200x801
非霍奇金淋巴瘤弥漫大b细胞淋巴瘤
图片尺寸729x683
图说 ▍非霍奇金淋巴瘤(下篇)
图片尺寸620x620
非霍奇金淋巴瘤一例
图片尺寸968x762
非霍奇金淋巴瘤以结外起病为主,临床上易合并骨髓纤维化,需警惕
图片尺寸650x410
现代非霍奇金淋巴瘤学
图片尺寸567x800
图说 ▍非霍奇金淋巴瘤(上篇)
图片尺寸620x620
显微镜下的非霍奇金淋巴瘤
图片尺寸1200x801
济南血液病医院科普:确诊为非霍奇金淋巴瘤,自体移植效果_患者_治疗
图片尺寸500x335
这种严重么非霍奇金淋巴瘤
图片尺寸980x1039
非霍奇金淋巴瘤吗? 求助!
图片尺寸1024x768
霍奇金淋巴瘤与非霍奇金淋巴瘤的相关介绍
图片尺寸534x400
2021年中国淋巴瘤药物行业概览
图片尺寸640x391
图说 ▍非霍奇金淋巴瘤(上篇)
图片尺寸620x620
小肠系非霍奇金淋巴瘤b细胞性弥漫大b细胞巴瘤哪个医院好
图片尺寸1024x768
图说 ▍非霍奇金淋巴瘤(下篇)
图片尺寸620x620
霍奇金淋巴瘤综述
图片尺寸1080x810
什么是霍奇金淋巴瘤非霍奇金淋巴瘤又是什么
图片尺寸640x4111